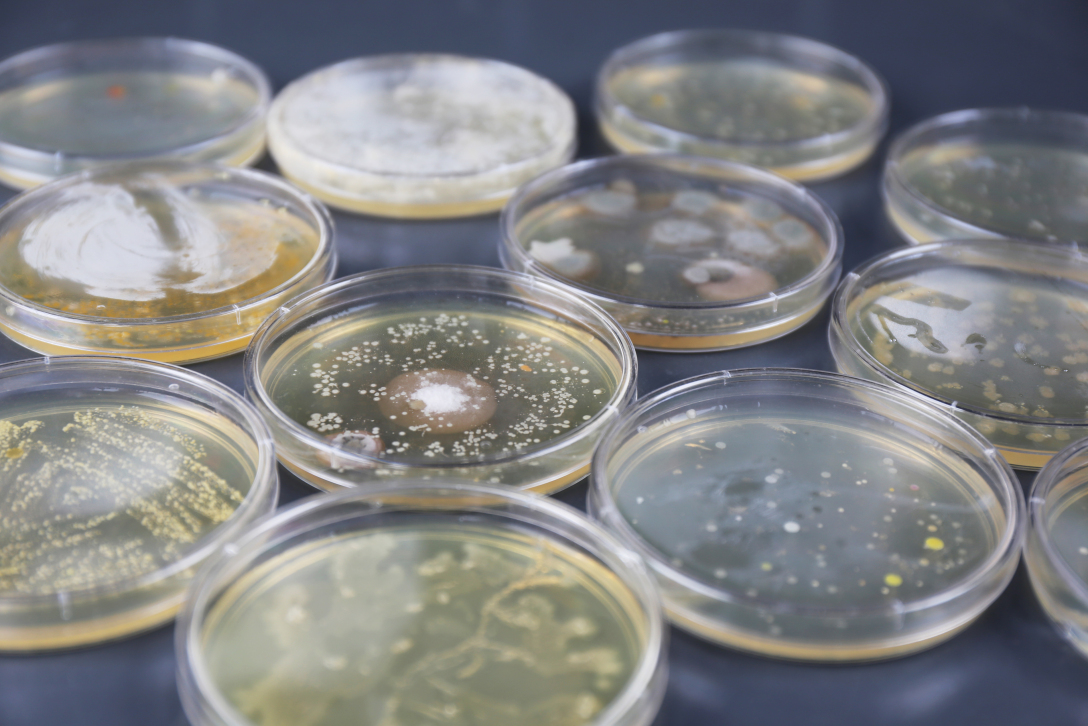
School of design, Central Academy of Fine Arts，Graduation exhibition，biotechnology，
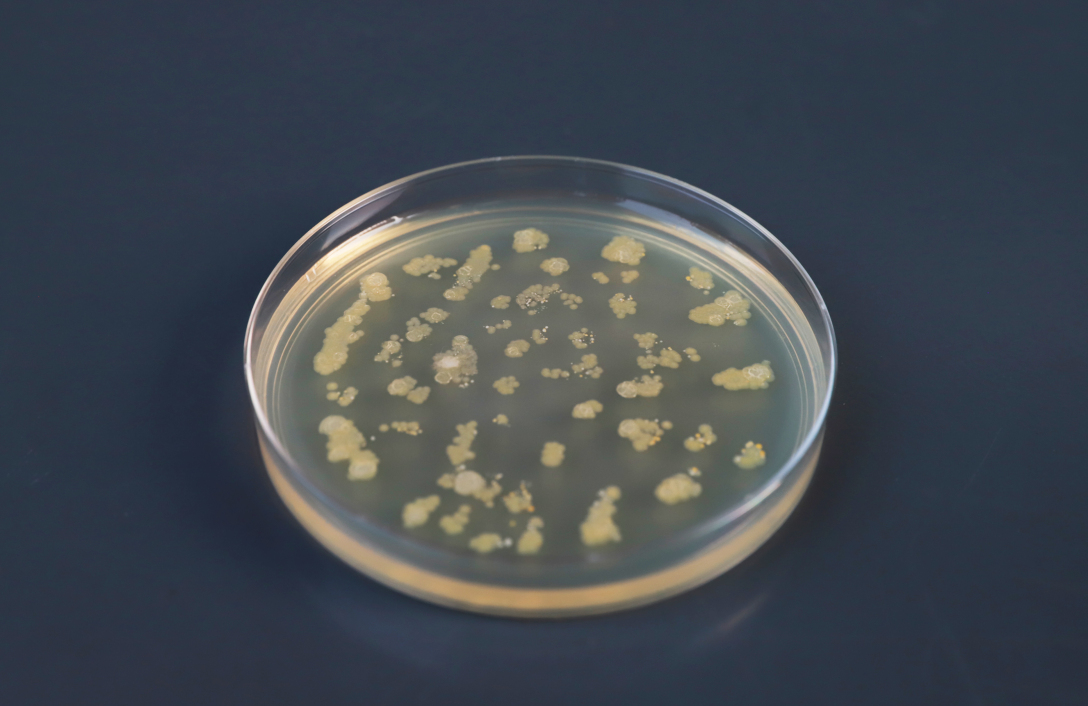
School of design, Central Academy of Fine Arts，Graduation exhibition，biotechnology，
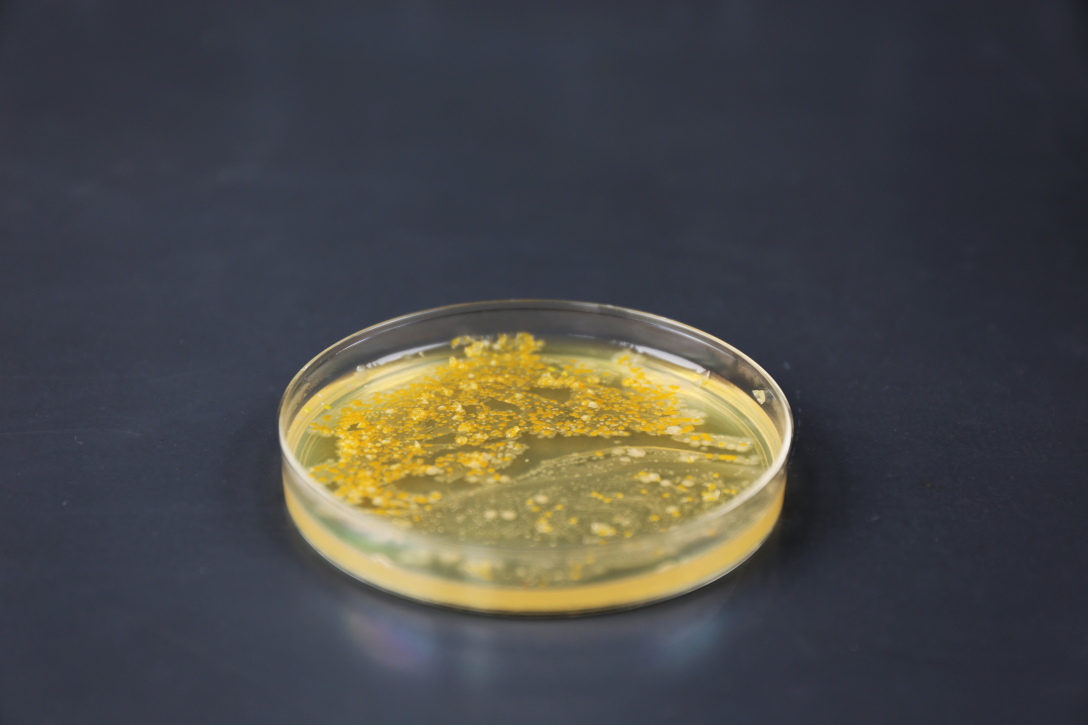
School of design, Central Academy of Fine Arts，Graduation exhibition，biotechnology，
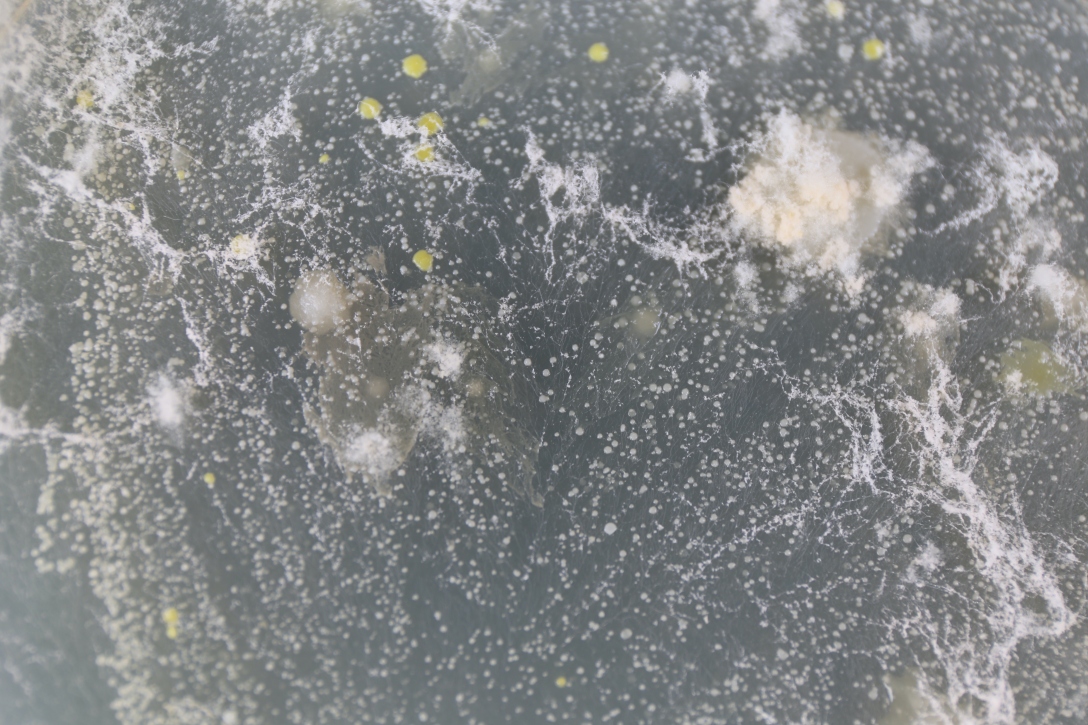
School of design, Central Academy of Fine Arts，Graduation exhibition，biotechnology，

The copyright of this work belongs to 中央美术学院设计学院. No use is allowed without explicit permission from owner.

New user?Create an account
Log In Reset your password.
Account existed?Log In
Read and agree to the User Agreement Terms of Use.

Please enter your email to reset your password
Comment Board (0)
Empty comment